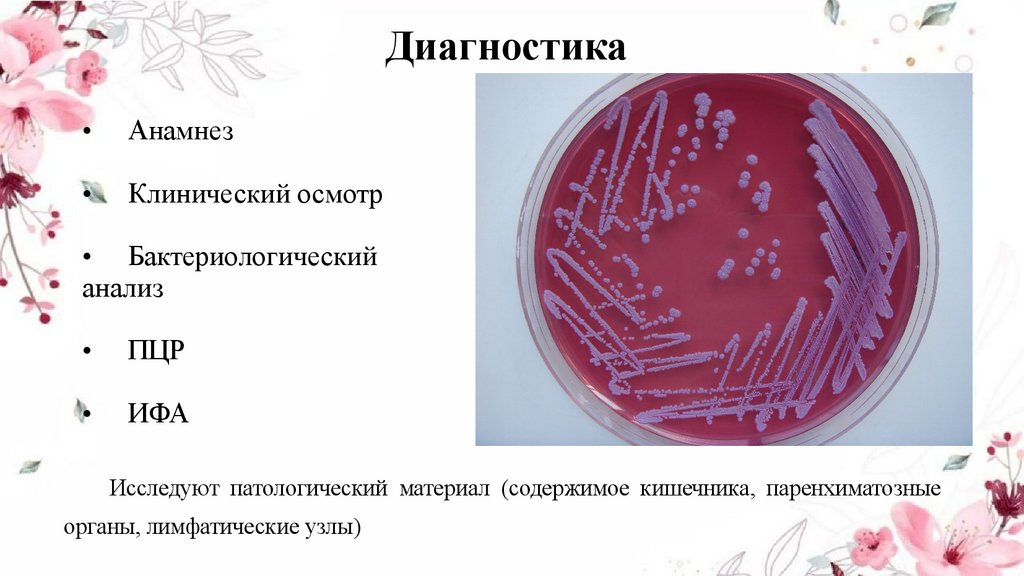

Похожие презентации:
Профилактика колибактериоза у телят: зоогигиенические и ветеринарно-санитарные мероприятия на предприятиях АПК
1.
Департамент образования Томской областиОГБПОУ «Томский аграрный колледж»
ПМ.02 «Проведение профилактических, диагностических и лечебных мероприятий »
Разработка комплекса профилактических, зоогигиенических и ветеринарносанитарных мероприятий против колибактериоза у телят на предприятиях АПК.
Выполнила:
Бурыхина Алина Ивановна, группа
В-308.
Специальность 36.02.01
«Ветеринария»
Руководитель: Головина Т.В
2025г.
2.
Обзор литературных данныхАктуальность темы: колибактериоз приводит к значительным убыткам в
животноводстве, так как снижает продуктивность животных и повышает
затраты на лечение и количество случаев гибели.
3.
Цель и задачиЦель исследования:
Разработка комплекса мероприятий профилактических, зоогигиенических и
ветеринарно-санитарных против колибактериоза у телят на предприятиях
АПК.
Задачи:
1. Обзор литературных данных
2. Анализ причин возникновения колибактериозом телят на предприятии
АПК
3. Разработка плана профилактических, зоогигиенических и ветеринарносанитарных мероприятий против колибактериоза у телят
4.
Характеристика заболеванияКолибактериоз (эшерихоз) — остро
протекающая
инфекционная
болезнь новорождённого молодняка
в первые дни жизни, вызываемая
бактериями рода Escherichia coli.
Имеет 3 формы течения заболевания:
септическую,
энтеритную
и
энтеротоксемическую
5.
ВозбудительEscherichia
coli
это
грамотрицательные, палочковидные
бактерии, имеющие способность к
адгезии
к
кишечной
стенке.
Патогенные штаммы производят
токсины,
которые
нарушают
нормальное
функционирование
кишечника и приводят к диарее.
Устойчивость:
1. В воде и почве - до 3-4 месяцев
2. На деревянных поверхностях до 2 месяцев
3. В навозе - до 2-3 недель.
6.
Клинические признакиСептическая форма
Энтеритная форма
Энтеротоксемическая
форма
• Молниеносное течение
• Понос с примесью
слизи и крови
• Признаки
интоксикации
• Повышение
температуры тела до 4141,5°С
• Угнетение
• Отказ от корма
• Острое течение
• Болезненность брюшной
стенки
• Водянистый зловонный
понос желто-белого цвета с
пузырьками газа и хлопьями
непереваренного молока
• Угнетение
• Повышение температуры
тела на 0,5-1°С
• Судороги
• Молниеносное течение
• Диарея слабо выражена или
ее нет
• Клинико-тонические
судороги
• Нарушение координации
• Скрежет зубами
• Повышенная тактильная
чувствительность
7.
Эпизоотологические данныеИнфицированное
молозиво
Заражение
Несоблюдении правил
асептики и антисептики во
время родов коров
Загрязненные
предметы ухода и посуда
Антисанитарные
условия содержания
• Сезонность: зимневесенний период
• Источник инфекции:
больные и переболевшие
животные
• Восприимчивы телята в
возрасте 3-7 дней
• Может сочетаться с
другими кишечными
инфекциями
8.
ПатогенезПроникновение в организм пероральным путем
Прилипание возбудителя к слизистой оболочке кишечника
Нарушение водно-электролитного баланса в организме
Появление угнетения, диареи, высокой температуры и отказа от корма
Быстрое обезвоживание, ацидоз и интоксикация
9.
ДиагностикаАнамнез
Клинический осмотр
• Бактериологический
анализ
ПЦР
ИФА
Исследуют патологический материал (содержимое кишечника, паренхиматозные
органы, лимфатические узлы)
10.
Профилактика- Регулярная уборка и дезинфекция помещений
- Обеспечение сухой и чистой подстилки
- Изоляция больных животных
- Кормление молозивом в первые часы жизни
- Использование качественного и
сбалансированного корма
- Предупреждение переохлаждения и стрессов
- Вакцинация телят
- Контроль качества воды и кормов
- Исключение контакта с переносчиками инфекции
- Своевременный мониторинг и лечение заболевших
телят
11.
Разработка комплекса профилактических, зоогигиенических иветеринарно-санитарных мероприятий против колибактериоза у телят.
Таблица №1 Комплексный план профилактических мероприятий против колибактериоза
12.
ЗаключениеРазработанные ветеринарно-санитарные мероприятия, включающие
регулярную дезинфекцию помещений, своевременную диагностику и
лечение больных животных, а также карантинные меры, позволяют
значительно снизить риск распространения инфекции, уменьшить
экономические
продукции.
потери
и
повысить
эффективность
производства

Медицина
Медицина Биология
Биология








